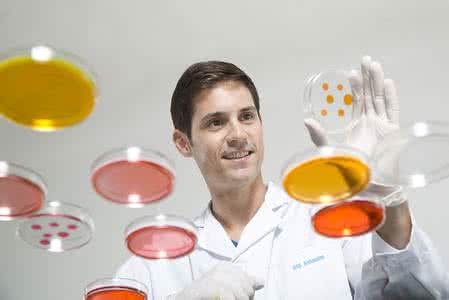

相关解答一:为什么这么多的人要吃虾青素啊?
楼主是要自己用?
1、虾青素是目前国际公认的最强的抗氧化剂,它的抗氧化性是VE的1000倍
2、30岁以后,人就开始被“氧化”,别惊奇,是这样的,因为体内的自由基开始增多,然而有没有足够的清楚自由基的物质在体内,导致我们的身体不断的被氧化,出现皱纹、疲劳、衰老、甚至是疾病都是有关的。虾青素的抗氧化作用就是有效地清除体内自由基,因此其效果毋庸置疑。
3、许多疾病的机理经证实也与氧化应激有关,如糖尿病、冠状动脉粥样硬化、痛风等,目前处于前沿的治疗方案就是抗氧化治疗。
至于虾青素的真实效果也只有自己吃了才知道,也许个体的差异也是原因。
相关解答二:过敏的人能吃虾青素吗
1.目前为止还没有发现有人吃了虾青素会过敏。
2.虾青素之所叫虾青素,是因为虾青素是在虾中提取出来的。而人吃虾过敏是对免疫球蛋白过敏,而不是对虾青素过敏。
3.由于人的体质原因,可能会有人对虾青素过敏,毕竟有人对大米和面粉也过敏。
相关解答三:什么人不能吃虾青素
现在市面上的纯天然虾青素是无副作用的。
参考资料:http://www.tudou.com/home/xiaqingsu/
相关解答四:什么人不宜吃虾青素
第一类:对海鲜过敏的人群
虾青素是从雨生红球藻、虾、蟹、贝壳等海洋生物中提取,而这些都是我们传统意义上的海鲜产品,因此,对海鲜过敏的人是坚决不能用的。
第二类:尿酸高的人群
虾青素因为是海洋生物提取,对人的酸碱平衡有极大的影响,因此尿酸高的人群是忌吃海鲜,而虾青素则更不能吃。因此要吃虾青素的人群一定先要确定自己是否有尿酸高的问题。最好是能去医院做相应的检测。就算是之前尿酸高,之后尿酸降下来的人群也在此列。
第三类:痛风的人群
痛风的病症原本就是人体酸碱失恒引起的,普遍痛风患者都存在尿酸高的现象,因此虾青素对痛风患者绝对不是福音。即使有些商家所谓的虾青素已经做了降敏处理。但还是要慎用。
相关解答五:三高的人,虾青素能吃的吗?
三高的人,有大部分会引起机体老化,虾青素正是最强的抗氧化产品,不但可以吃,还要多吃。我给家里人买的是麦弗逊公司的虾青素和盐藻。
相关解答六:什么人不宜吃虾青素
虾青素,原名雨生红球藻,所以是藻类提取物,基本上没有什么人不能吃的。没关系的。
相关解答七:虾青素适合什么人吃
1.预防和治疗糖尿病的发生发展,降低糖化血红蛋白含量。预防和治疗糖尿病并发症,如糖尿病肾病损害,糖尿病脑病,糖尿病病足,糖尿病心脏病,糖尿病眼病等。
2.缓慢平稳降低平均动脉血压。
3.阻止RNA,DNA的氧化分解(减少嘌呤产生),用于痛风慢性期的治疗。
4.阻止低密度脂蛋白LDL氧化成Ox-LDLL,显著提升高密度脂蛋白HDL和脂联素,阻止动脉粥样硬化。降低心脏病和脑血管病的风险。
5.阻止和延缓老年性眼底黄斑变性(眼底视网膜的动脉粥样硬化)。
6.修复幽门螺杆菌感染导致的胃及12指肠溃疡,主要是阻止细胞膜和RNA和DNA的氧化损伤。
7.大剂量的虾青素可以抑制膀胱癌和结肠癌。
8.预防和治疗老年性痴呆(阿尔茨海默综合征)和帕金森综合症。已经被认定为帕金森综合症最有效的保健品。
9.修复因为胶原蛋白和RNA被氧化损伤导致的眼角鱼尾纹、颈纹、黑眼圈、眼袋和色斑等。
10.缓解因运动导致的疲劳和减少运动后的乳酸,减轻疼痛,显著增强体力,改善阳痿和早泄等病症。
相关解答八:虾青素适合什么人吃?
答:适合所有成年人吃,可以抗衰老,抗氧化,对皮肤也好,还可以预防心脑血管疾病 然后可以根据打电话人针对说一些:
1,女性:像一般女性服用可以抗衰老,有的女士年龄大些容易会有色斑,虾青素还可以很好的淡化色斑,美白,提高免疫力
2,男性:像一般男性服用可以抗衰老,提高免疫力,抗氧化,预防心脑血管疾病,抑制糖尿病病变,有的男生经常吸烟,吸烟对身体的 氧化非常厉害,吸烟的人更应该吃虾青素来抗氧化,当然最好还是戒烟的同时吃虾青素
相关解答九:什么人不宜吃虾青素
虾青素是保健药物,经济条件允许的人,都可以吃的,有益无害。
相关解答十:虾青素对人体有什么好处
一、眼和中枢神经系统的保护作用
虾青素很容易通过血脑屏障和细胞膜,能有效地防止视网膜的氧化和感光细胞的损伤,以及对中枢神经系统尤其是对大脑起到保护作用,尤其是针对老年性视网膜黄斑变性的效果要比叶黄素更加显著。
二、防紫外线辐射,防止皮肤老化
众所周知,紫外线辐射是导致表皮光老化和皮肤癌的重要原因。而虾青素的强抗氧化性可能使它成为潜在的光保护剂,有效清除引起皮肤老化的自由基,阻止皮肤光老化。
三、预防心血管疾病
虾青素在体内具有显著升高HDL和降LDL的功效,可用来预防动脉硬化、冠心病和缺血性脑损伤。
四、增强免疫力
虾青素有很强的诱导细胞分裂的活性,具有重要的免疫调节作用。
五、缓解运动疲劳。增强机体能量代谢
当机体运动时肌肉会释放自由基,这些自由基若不被抗氧化剂及时处理,就会产生氧化压力,致使肌肉酸痛或肌肉组织的损伤。而虾青素可以作为一种抗氧化剂抑制自由基对机体的氧化损害作用。增加肌肉力量和肌肉耐受力,迅速缓解运动疲劳,减轻剧烈运动后产生的迟发性肌肉疼痛。
百度搜索“爱华网”,专业资料,生活学习,尽在爱华网
 爱华网
爱华网



